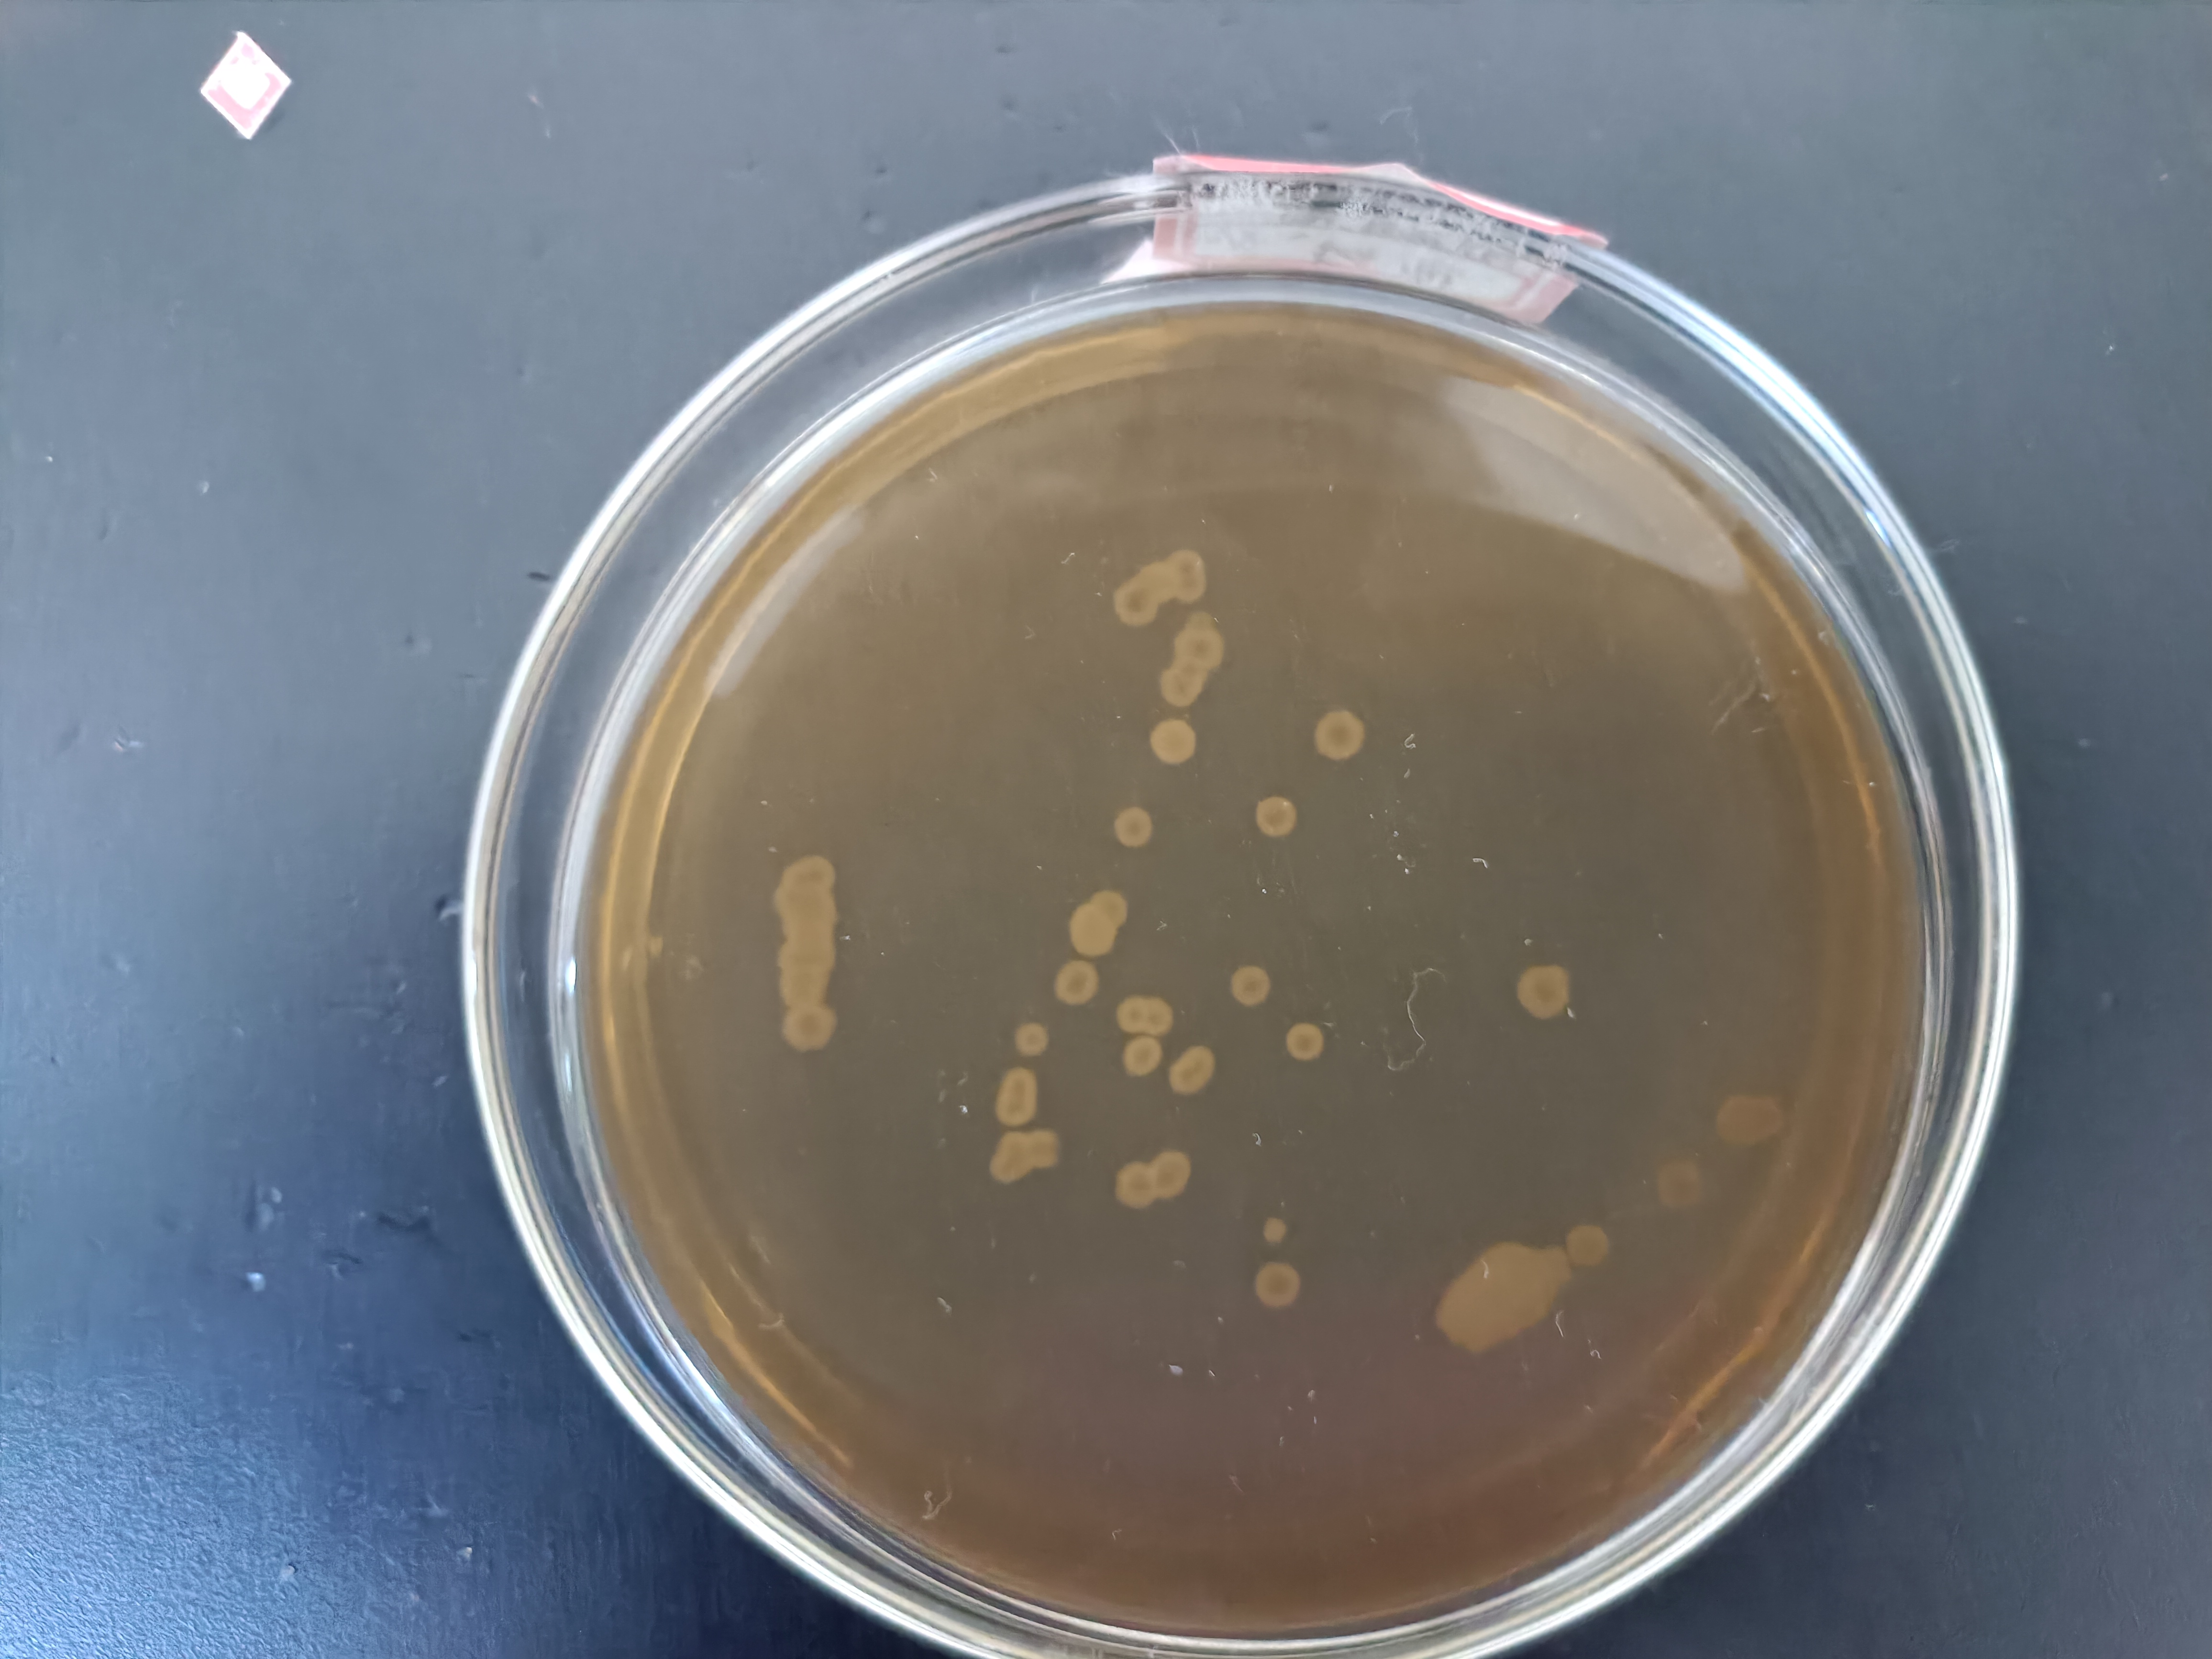
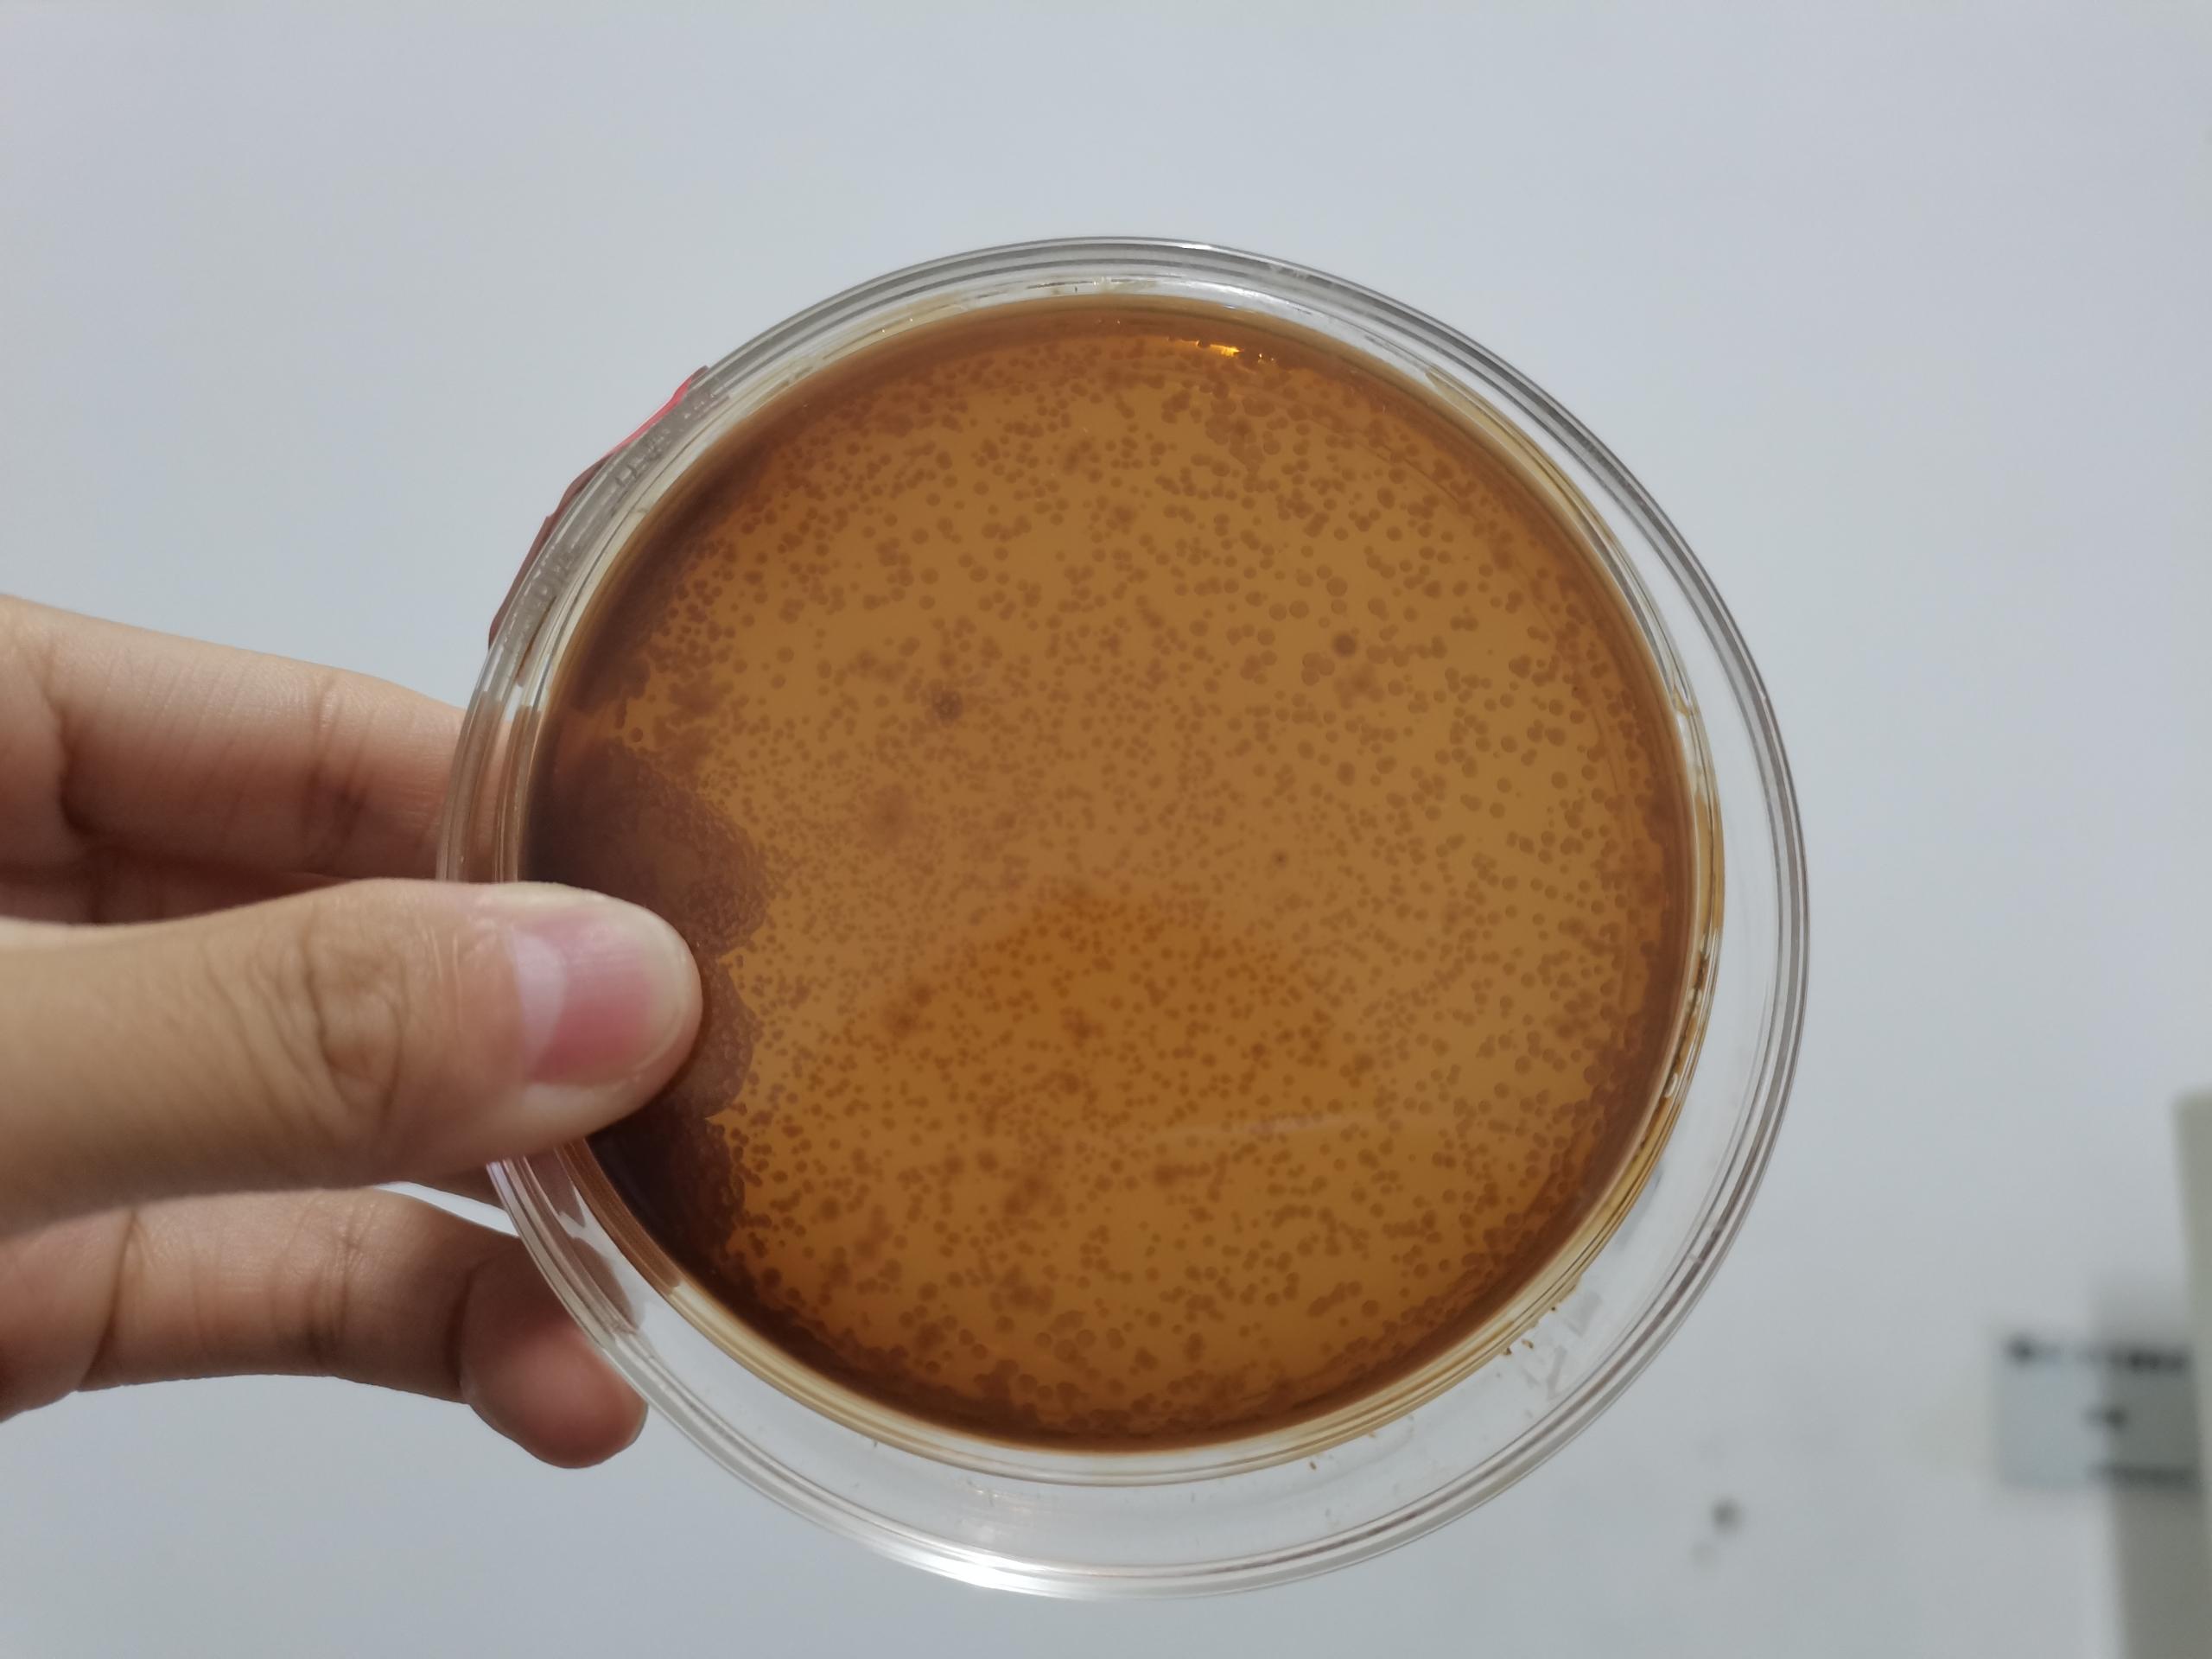
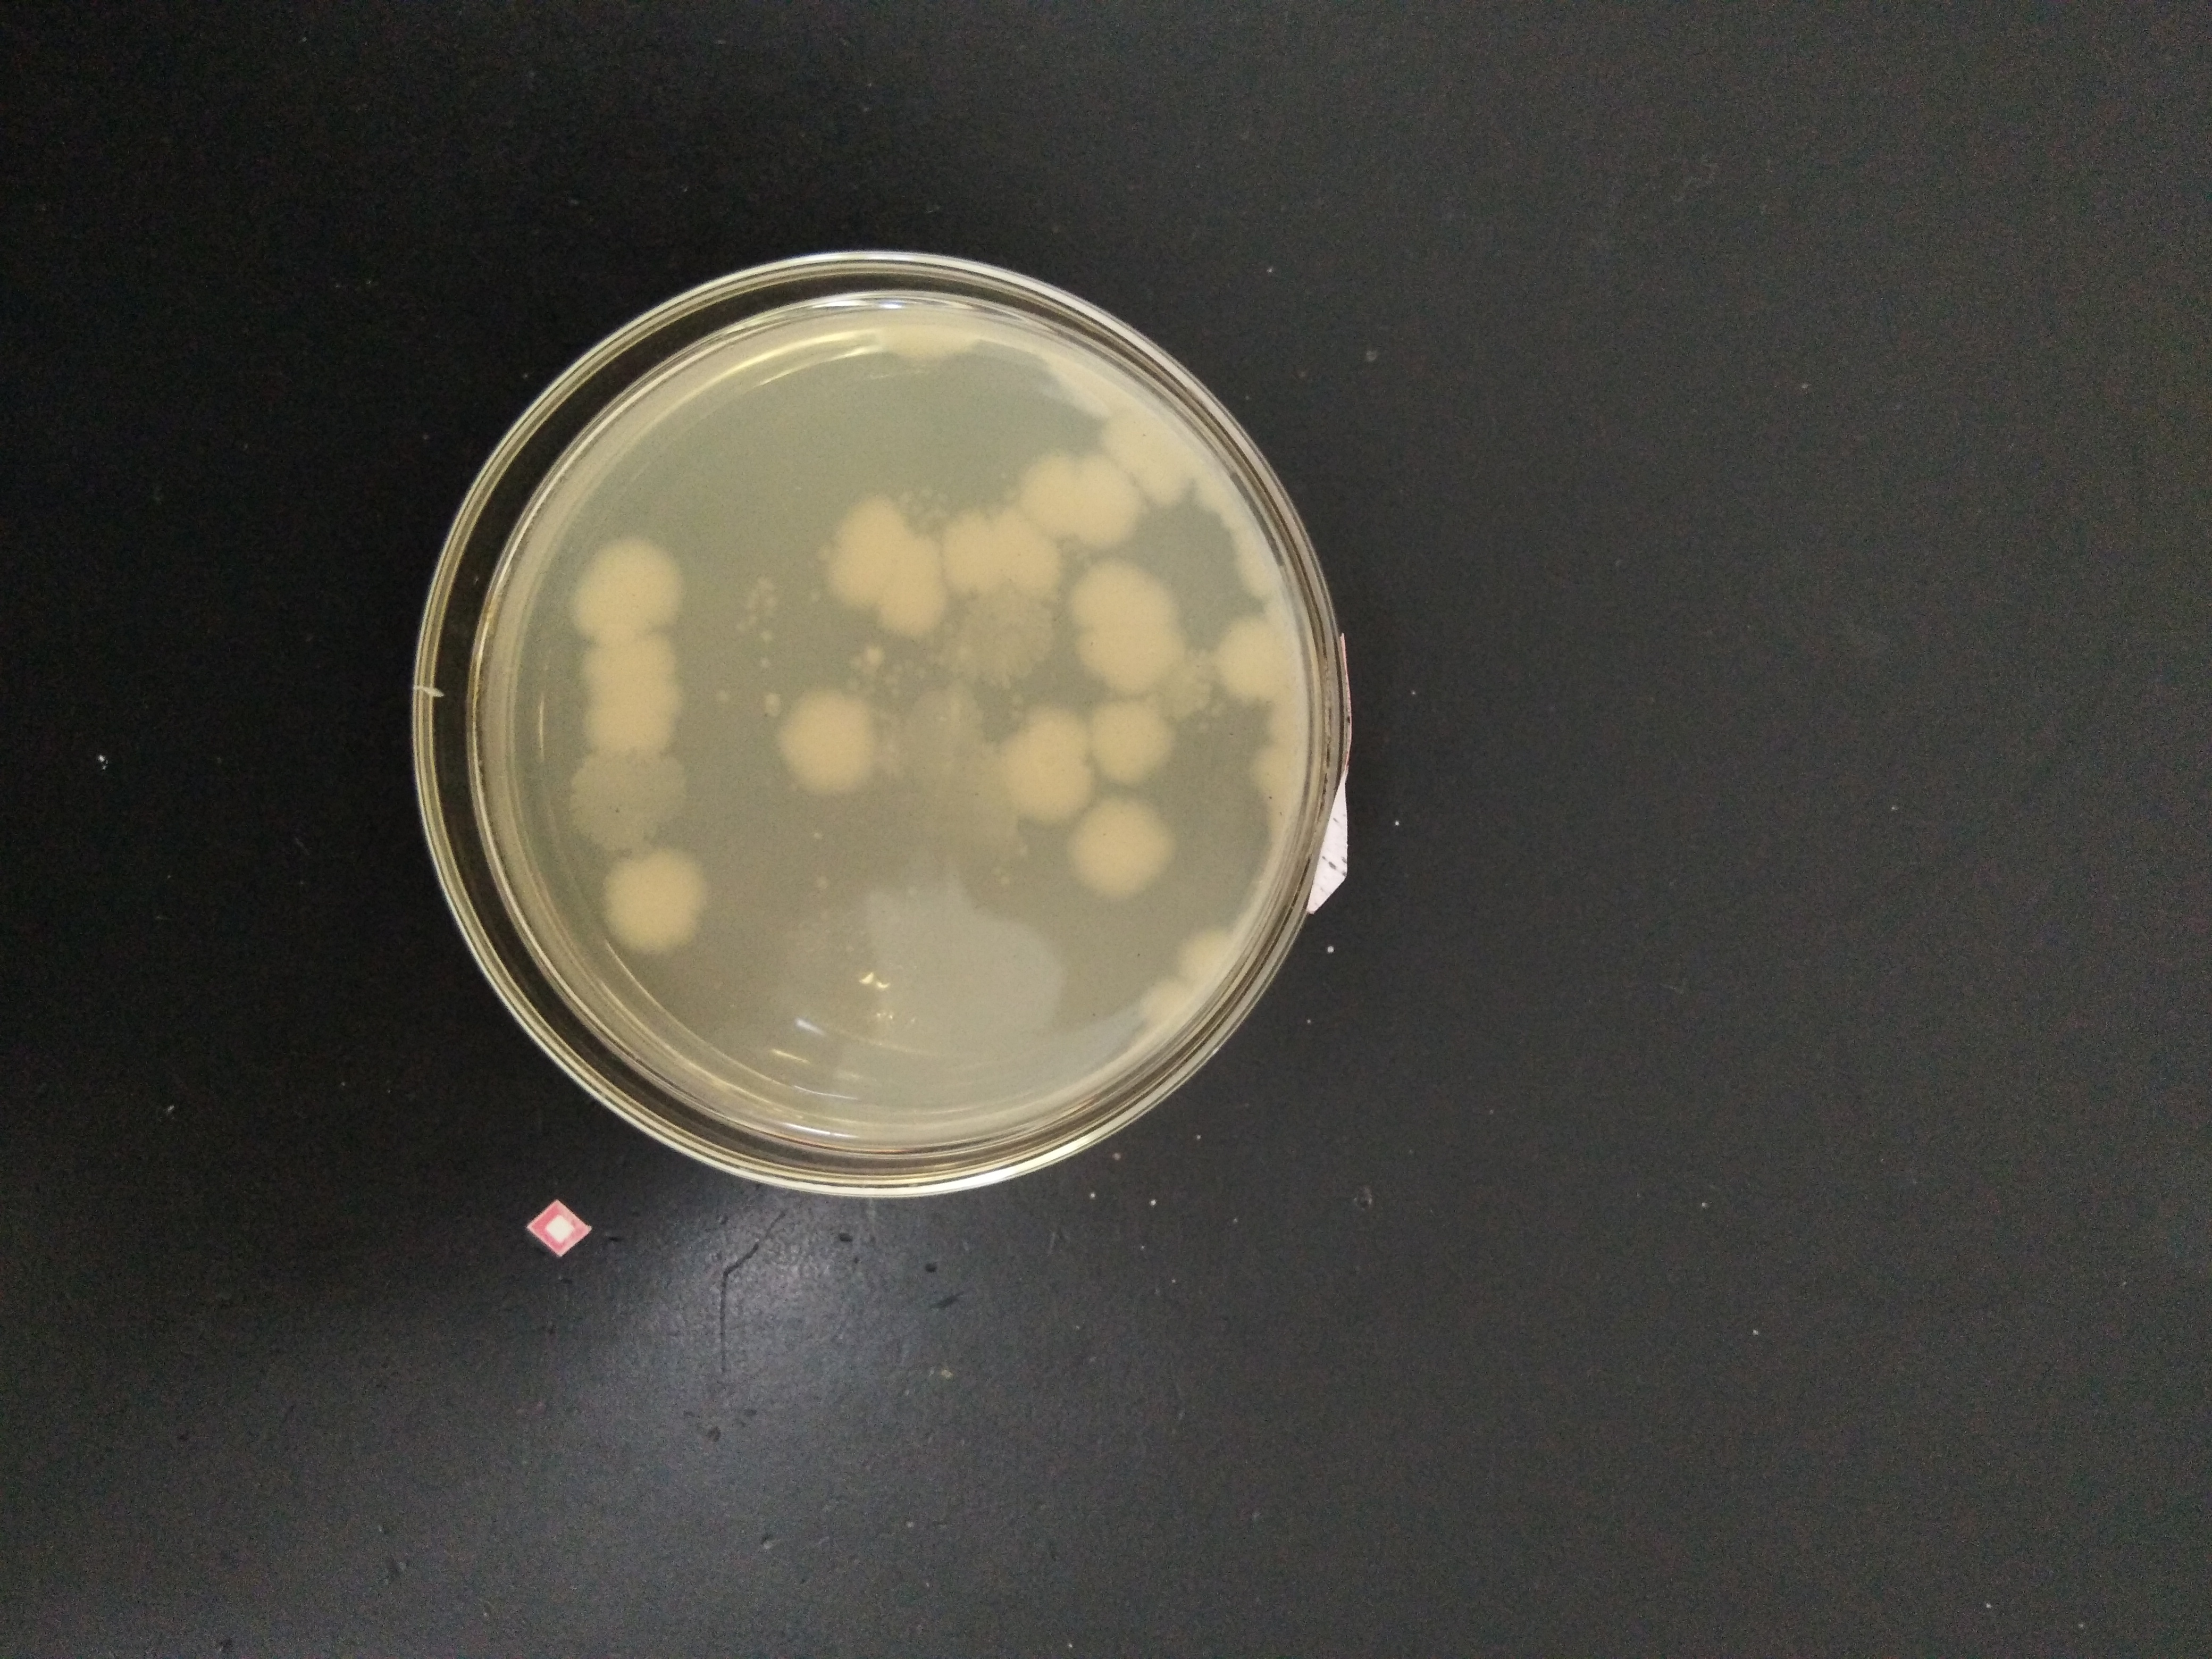

微生物知识及实验技能培训

















微生物知识及实验技能培训 |
|
| 2022年8月18日 | |
| 2022年8月10日至16日,北京博源恒升高科技有限公司邀请河北工业大学张建斌教授在江西永丰博源实业有限公司为两地的技术研发人员进行了微生物学知识学习讲座和实验操作技能培训。 | |
| 参加培训的人员有永丰博源实业有限公司技术研发部的全体工作人员:邓品蓉、袁冬秀、李世嵩、郭文勤、占善亮、肖雨霞,北京博源恒升高科技有限公司研发部的王跃发、汉春利、刘家旭、刘秀艳。博源实业公司总经理罗世明和常务副总经理万明金参加了培训预备会,罗世明总经理通过公司的DDS生物脱硫技术的特点和应用情况,说明了对公司研发人员进行微生物相关知识技能培训的必要性和重要性,细菌是这个技术核心中的核心,对微生物知识的了解,能够提高我们的工作能力和效率,提升我们为用户服务的深度和广度。 | |
 |
|
| 培训内容分为两部分,张建斌教授根据我们公司微生物应用情况有针对性地讲解了有关的微生物学知识,让大家对公司的生物脱硫技术有了进一步的认识,加强了工作的目的性。另一方面通过大量的实践操作,人人动手,从培养基配制、灭菌、平板与斜面制作接种、菌种的复壮与观察计数、细菌扩增培养等方面进行了实操训练,使培训人员尽快学会基本的相关实验技能。 | |
 |
|
 |
 |
 |
 |
 |
 |
 |
 |
|
|
 |
 |
 |
|
 |
|